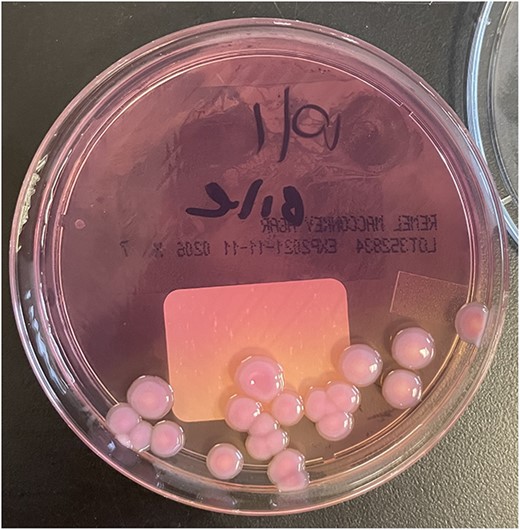
Colonies of R. Planticola from gallbladder bile, growing on a MacConkey agar plate.

-
PDF
- Split View
-
Views
-
Cite
Cite
Gerald Doherty, Jason Kreinces, Fabiola Souza, Daniel E Kim, Chronic cholecystitis from Raoultella planticola infection associated with adenomyomatous hyperplasia, Journal of Surgical Case Reports, Volume 2022, Issue 11, November 2022, rjac529, https://doi.org/10.1093/jscr/rjac529
Close - Share Icon Share
Abstract
A 67-year-old woman presented with lower abdominal pain, diarrhea, nausea, vomiting and fatigue. Computed tomography was suggestive of cholecystitis, but neither ultrasound nor magnetic resonance cholangiopancreatography found evidence of cholecystitis or biliary ductal dilatation. The patient was started on piperacillin-tazobactam, and blood cultures revealed gram-negative-rod bacteremia. Laparoscopic cholecystectomy was performed and bile cultures grew Raoultella planticola susceptible to ciprofloxacin, which was identical to the speciation of her positive blood cultures. In addition, pathology revealed adenomyomatous hyperplasia of the gallbladder and chronic cholecystitis. Unlike other cases of R. planticola cholecystitis, our patient had no significant risk factors for the infection—no history of immunosuppression, diabetes mellitus, nor underlying malignancy. We discuss the current knowledge of R. planticola infection in the setting of chronic cholecystitis and adenomyomatous hyperplasia.
INTRODUCTION
Raoultella planticola is a facultative anaerobic, non-motile, gram-negative bacillus [1]. Although considered a rare pathogen, recent literature indicates that it is an increasingly important infectious organism and may be more common than current data suggests [2]. Infections caused by the organism are mostly nosocomial pneumonias, however, cases of cystitis, cholangitis, cholecystitis and cellulitis are also cited [3]. We report a 67-year-old woman who presented with bacteremia and chronic cholecystitis caused by R. planticola, who was also found with adenomyomatous hyperplasia (AMH) of the gallbladder.
CASE REPORT
A 67-year-old healthy woman presented to the emergency department (ED) with lower abdominal pain. She reported 1 week of moderate ‘band-like’ abdominal pain that radiated to her back, nausea and vomiting, fatigue and watery diarrhea. She denied upper respiratory symptoms, recent travel, and sick contacts. Her only surgery was a laparoscopic ovarian cyst removal 1-year ago.
Her vital signs in the ED were temperature of 37.9°C, heart rate of 124 beats per minute, blood pressure 92/50 mmHg and oxygen saturation of 96% on room air. Abnormal laboratory tests included white blood cell count of 15.4 × 1000/μl with 94.9% neutrophils, alanine aminotransferase 207 U/l, aspartate aminotransferase 462 U/l, alkaline phosphatase 234 U/l, total bilirubin 2.5 mg/dl, lactic acid 2.0 mmol/l and procalcitonin of 18.94 ng/ml. SARS-CoV-2 RNA nasal swab was negative.
Right upper quadrant ultrasound revealed a distended gallbladder with multiple small calculi but no wall thickening nor pericholecystic fluid (Fig. 1). Intra- and extra-hepatic biliary ducts and the common bile duct were not dilated. A sonographic Murphy sign was not elicited. Computed tomography of her abdomen and pelvis revealed moderate hepatomegaly with heterogeneous enhancement, prominent hepatic veins, periportal edema and pericholecystic fluid (Fig. 2).

Abdominal ultrasound showing a distended gallbladder with multiple small calculi. There is no gallbladder wall thickening nor pericholecystic fluid.

Axial and coronal images of a computed tomography showing a gallbladder (arrows) with multiple gallstones and pericholecystic fluid. Moderate hepatomegaly with heterogeneous enhancement and prominent hepatic veins are also present.
She received normal saline boluses, intravenous piperacillin-tazobactam and vancomycin, and was admitted for sepsis secondary to suspected cholangitis or cholecystitis. Magnetic resonance cholangiopancreatography found no evidence for common bile duct stone, cholecystitis or biliary ductal dilatation. Two blood cultures drawn on admission showed gram-negative rods, so piperacillin-tazobactam was continued. Due to the likelihood of a biliary source for sepsis, laparoscopic cholecystectomy with intraoperative cholangiogram was performed revealing an inflamed gallbladder with multiple stones and no filling defects on cholangiogram (Fig. 3). Gallbladder pathology was consistent with chronic cholecystitis with cholelithiasis and AMH (Fig. 4). The blood cultures and an intraoperative bile culture both grew R. planticola (Fig. 5), which was susceptible to ciprofloxacin. The patient recovered well from her surgery and was discharged home with a 2-week course of oral ciprofloxacin.

Intraoperative cholangiogram with contrast within the cystic, common hepatic and common bile duct with no filling defect to suggest choledocholithiasis. Contrast can be seen within the duodenum (arrows).

Left: Low power H&E of cystically dilated benign biliary glands accompanied by smooth muscle hypertrophy of the gallbladder wall consistent with adenomyomatous hyperplasia. Right: Low power section of fibrotic gallbladder wall with chronic inflammation consistent with chronic cholecystitis.
Colonies of R. Planticola from gallbladder bile, growing on a MacConkey agar plate.
DISCUSSION
The Raoultella sp. was originally a member of the Klebsiella sp. but later reclassified into its own genus. The reported rise in R. planticola cases may be due to better identification through molecular analysis and laboratory tests [2]. Common risk factors for infection include immunosuppression, indwelling catheters, ICU stay, diabetes mellitus and malignancy [3, 4]. However, our patient had none of these risk factors.
Although R. planticola is not considered a highly virulent organism, its mechanism of pathogenesis and antibiotic reactivity have not been fully elucidated. Known bacterial factors that contribute to its pathogenesis of human disease include lipopolysaccharide, a polysaccharide capsule, fimbriae, siderophores, hydrolytic enzymes, bacteriocins and beta-lactamases [1, 5, 6]. Many of these virulent factors are shared with the Klebsiella sp, but unique to the Raoultella sp. is its ability to produce histamine [7]. Raoultella planticola can also create a biofilm, protecting it from immune defenses and antibiotics [7].
Raoultella sp. are naturally resistant to aminopenicillins due to the expression of beta-lactamases [3]. Raoultella planticola cases have largely been treated with third or fourth generation cephalosporins, carbapenems or fluoroquinolones. Consistent with previous reports of R. planticola infections, the isolated bacterium in this case was susceptible to ciprofloxacin. In addition to antibiotic resistance, Koc et al. [8] reported resistance to disinfectants, which is especially important given the organism’s identification in nosocomial infections. As Raoultella sp. can acquire antibiotic resistance genes, increasing infections from multi-drug resistant strains are expected in the future.
Macroscopically, the gallbladder was congested with purple discoloration, filled with multiple black bosselated calculi and a 0.7-cm fundic polyp. Microscopy revealed AMH, a reactive nonneoplastic lesion characterized by cystically dilated biliary glands accompanied by smooth muscle hypertrophy of the gallbladder wall. AMH is found in approximately 10% of cholecystectomies [9]. Symptoms of AMH are generally nonspecific. Most patients present with right upper quadrant abdominal pain. Our patient had the fundal variant of AMH, which is most common.
The exact cause of AMH is not fully understood. The proposed pathogenesis of restricted bile excretion and increased gallbladder luminal pressure include neurogenic dysfunction, insufficient embryological development of the gallbladder bud, cholelithiasis and cholecystitis. Chronic stimulation by gallstones and cholecystitis leads to epithelial proliferation and hypertrophy of the muscles of the gallbladder wall [10]. This proliferation may also result in narrowing of the bile duct, further increasing pressure and leading to cystic dilatation of glands [10]. A morphologic and immuno-phenotypical study on AMH reported significantly more myofibroblast proliferation in AMH when compared with chronic cholecystitis, suggesting that the underlying pathophysiology in AMH is due to derangements in epithelial-stromal interaction [11].
Our case supports the association between chronic cholecystitis and AMH, but the temporal and causal relationship is difficult to establish and is a potential focus for future research. AMH’s malignant potential and relationship to gallbladder carcinomas are controversial. Previous studies report that the segmental type of AMH has the highest risk of developing into a carcinoma, whereas the fundal type does not have a strong association with malignancy [12]. It is unclear if AMH has a connection to R. planticola infection; additional surveillance is necessary to determine if a relationship exists.
CONFLICT OF INTEREST STATEMENT
None declared.
FUNDING
No funding was received to assist with the preparation of this manuscript.
CONSENT STATEMENT
Written informed consent was obtained from the patient for publication of this case report.